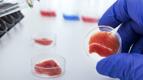

Branschorganisationen Svenskt Kött lanserar nu en digital köttskola, en grundutbildning riktad mot anställda i dagligvaruhandeln men som även är öppen för alla som är intresserade.
– Det finns ett växande intresse för kött gällande hantering och kvalitet. Det hänger i sin tur samman med ett generellt ökat intresse för hållbar konsumtion och matlagning hos konsumenterna och det vill Svenskt Kött möta, säger Elisabet Qvarford, vd på Svenskt Kött, i ett pressmeddelande.
Kursplanen ligger på nätet och den som vill kan där nå över 50 korta lektioner som går att följa på mobil, padda eller dator.
Efter genomförd utbildning kan den som vill få avlägga prov och tillgodogöra sig ett diplom. Där finns även specialutbildning för butiksmedarbetare.
Syftet är att höja grundnivån på köttkunskap i butik. Målgruppen för utbildningen är personal inom dagligvaruhandeln, men Köttskolan.se är öppen för alla och helt gratis, säger Elisabet Qvarford.